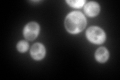
YBL076C
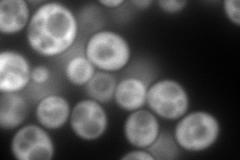
YBL076C
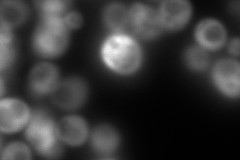
YBL076C
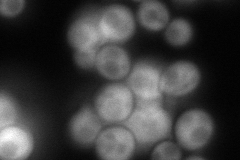
YBL076C
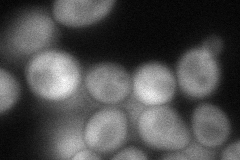
YBL076C
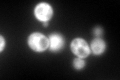
YBL076C

View description
Cytoplasmic isoleucine-tRNA synthetase, target of the G1-specific inhibitor reveromycin A
Localization:
Intensity:
Fold change:
Significance:
-
C’ GFP library in SD
cytosol406.77 -
N' NOP1pr-GFP in SD
cytosol272.129 -
N' TEF2pr-mCherry in SD
cytosol65.1924 -
N' NATIVEpr-GFP in SD
cytosol157.866 -
N' TEF2pr-VC and Cyto-VN in SD
cytosol84.6035 -
C’ GFP library in SD+DTT

cytosol388.570.95No -
C’ GFP library in SD+H2O2
cytosol405.630.99No -
C’ GFP library in Starvation Media

cytosol193.950.47Yes -
C’ GFP library on the background of Pup2-DaMP

cytosol -
C’ GFP library on the background of CCT mutant

cytosol451.6351.11028No
